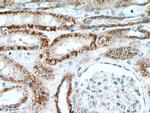
INPP5J Antibody in Immunohistochemistry (Paraffin) (IHC (P))

Search
Proteintech
INPP5J Polyclonal Antibody
{{$productOrderCtrl.translations['antibody.pdp.commerceCard.promotion.promotions']}}
{{$productOrderCtrl.translations['antibody.pdp.commerceCard.promotion.viewpromo']}}
{{$productOrderCtrl.translations['antibody.pdp.commerceCard.promotion.promocode']}}: {{promo.promoCode}} {{promo.promoTitle}} {{promo.promoDescription}}. {{$productOrderCtrl.translations['antibody.pdp.commerceCard.promotion.learnmore']}}
产品信息
21417-1-AP
种属反应
已发表种属
宿主/亚型
分类
类型
抗原
偶联物
形式
浓度
规格
纯化类型
保存液
内含物
保存条件
运输条件
产品详细信息
Immunogen sequence: RVGFRHCKD YVAYVRAKHE DVDGNTYQVT FSEESLPKGH GDFILGYYSH NHSILIGITE PFQISLPSSE LASSSTDSSG TSSEGEDDST LELLAPKSRS PSPGKSKRHR SRSPGLARFP GLALRPSSRE RRGASRSPSP QSRRLSRVAP DRSSNGSSRG SSEEGPSGLP GPWAFPPAVP RSLGLLPALR LETVDPGGGG SWGPDREALA PNSLSPSPQG HRGLEEGGLG P (777-1006 aa encoded by BC109288)
靶标信息
Inositol and phosphatidylinositol phosphates are important for numerous cellular processes, including neuronal survival and signal transductions from growth factors, neurotransmitters and G protein coupled receptors. INPP5J (inositol polyphosphate-5-phosphatase J), also known as phosphatidylinositol 4,5-bisphosphate 5-phosphatase A, PIPP (proline-rich inositol polyphosphate 5-phosphatase), PIB5PA or INPP5, is a 1,006 amino acid cytoplasmic protein that assists in the conversion of inositol 1,4-bisphosphate from inositol 1,4,5-trisphosphate. Expressed in lung, stomach, kidney, brain, small intestine and heart, INPP5J localizes to membrane ruffles, where it may also participate in modulating inositol and phosphatidylinositol polyphosphate-binding proteins. Encoded by a gene located on human chromosome 22, INPP5J undergoes alternative splicing to produce three isoforms.
仅用于科研。不用于诊断过程。未经明确授权不得转售。
生物信息学
蛋白别名: Inositol polyphosphate 5-phosphatase J; phosphatidylinositol (4,5) bisphosphate 5-phosphatase, A; phosphatidylinositol (4,5)bisphosphate 5-phosphatase homolog; Phosphatidylinositol 1,3,4,5-tetrakisphosphate 5-phosphatase; Phosphatidylinositol 1,4,5-trisphosphate 5-phosphatase; Phosphatidylinositol 4,5-bisphosphate 5-phosphatase A; Proline-rich inositol polyphosphate 5-phosphatase; unnamed protein product
基因别名: Inpp; INPP5; INPP5J; PIB5PA; PIPP
UniProt ID: (Human) Q15735, (Mouse) P59644, (Rat) Q9JMC1
Entrez Gene ID: (Human) 27124, (Mouse) 170835, (Rat) 171088